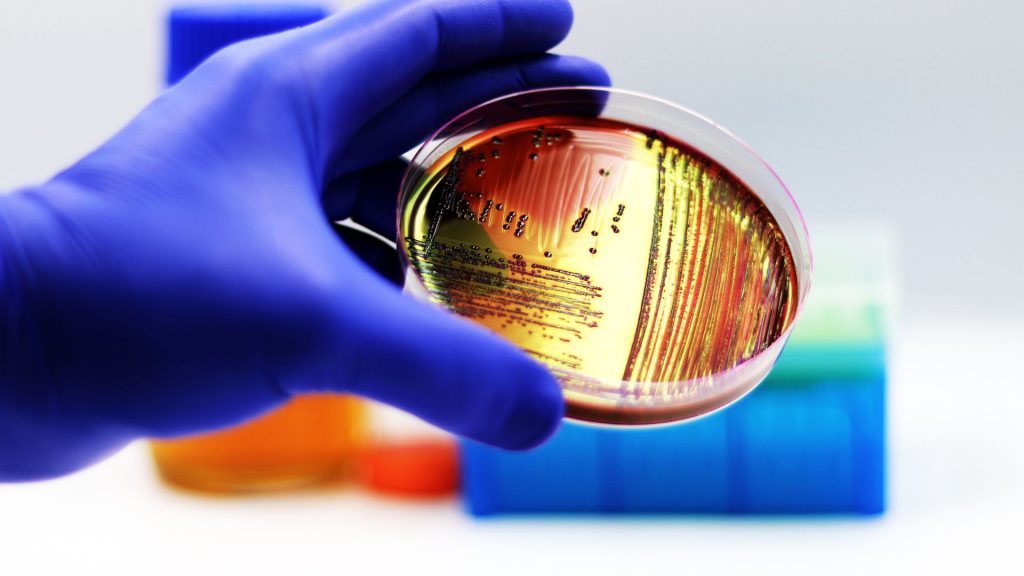
placa petri

PhD en Biotecnología Selene Gómez
Únete a la aventura de explorar el mundo microbiano
¡Prepárate para ver lo pequeño de una manera muy grande!
¡Bienvenidos a mi rincón microbiano!
Aquí encontrarás un espacio dedicado a explorar el fascinante mundo de los microorganismos. Desde las últimas investigaciones en microbioma hasta datos curiosos que te sorprenderán de los microbios, este sitio es una puerta abierta hacia un universo invisible, pero vital para la vida en la Tierra.
Como microbióloga apasionada, mi objetivo es compartir contigo los avances más recientes, reflexiones y descubrimientos que muestran cómo estos diminutos seres impactan nuestra salud, el medio ambiente y mucho más. Te invito a sumergirte en este viaje científico, donde lo pequeño se vuelve inmenso con cada historia y cada post es una oportunidad para aprender algo nuevo.
¡Gracias por visitar, y espero que disfrutes explorando tanto como yo disfruto escribiendo!
Post recientes
En esta sección, te muestro los últimos post sobre el universo de los microorganismos. Cada artículo está diseñado para llevarte a través de temas sorprendentes y reveladores, desde los secretos de los microorganismos hasta los avances en biotecnología y microbioma.
Acompáme en este viaje para descubrir cómo estos pequeños organismos impactan en la medicina, el medio ambiente, la tecnología, y mucho más. Te invito a sumergirte en las publicaciones más recientes, donde cada lectura te acercará a los secretos de lo invisible.
¿Están vivos los virus?
¿Cuántas bacterias pueden vivir en el intestino de una persona?
¿Cuántas bacterias se pueden producir a partir de una bacteria en una hora?
¿Cuánto pesa una bacteria?
Secretos del microbioma
El microbioma es el conjunto de microorganismos, como bacterias, virus, hongos, arqueas y protozoarios que habitan en un ambiente específico, como el cuerpo humano, los suelos, los océanos, etc. interactuándo entre sí y con el huésped o ambiente.
Microbios en el cine
Desde virus devastadores hasta bacterias con habilidades increíbles, el mundo microscópico ha sido una fuente de inspiración para películas que nos llevan al límite de la ciencia y la imaginación. En esta sección, puedes ver cómo el cine ha representado a estos diminutos protagonistas, mezclando ciencia real con fascinantes toques de ficción. Se analizan los aspectos científicos detrás de algunos de los microbios más famosos del cine y descubrimos qué tan cerca —o lejos— están de la realidad. Acompáñanos en este recorrido por las historias donde lo pequeño tiene un impacto enorme y descubre cómo el séptimo arte nos ha enseñado a temer, respetar y hasta admirar el poder invisible de los microbios.